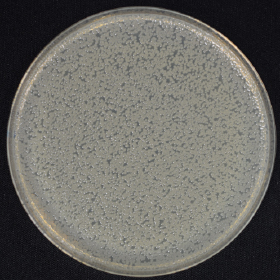
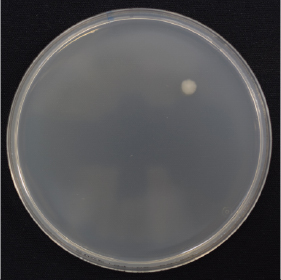

ABOUT

オゾン水とは
ウイルスや菌の「除菌・脱臭」をサポートする水です。
原料は水だけなので、安心して使うことができます。
時間の経過で酸素や水に戻るため、
残留の心配もなく人にも環境にも配慮した水です。
FEATURE
AQUA OZONEとは
生成したオゾンをしっかり水に溶解する新技術
99%以上の除菌水※1を生成する
オゾン水除菌ユニット

※イメージ画像:試験結果をもとにして作成
水道水を電気分解し、オゾン水を生成

工学院大学の独自技術を実装したユニット構造により、生成したオゾンをしっかりと水中へ溶解。オゾンガスの発生を抑え、オゾン水として広範囲へ行き渡らせることで、除菌効果・脱臭効果を実現します。
※1[試験機関](株)衛生微生物研究センター[試験番号]2021D-BT-11017[試験方法]オゾン水に菌液を接種し、残存した菌数を測定。[試験結果]接触時間10秒で99%以上除菌。(実使用での実証効果ではありません。使用環境により効果は異なります。)
PROJECT
EXAMPLE
AQUA OZONE
搭載商品事例
\ 商品・事業連携可能なパートナー企業さま募集中 /
資料請求・お問合せPRODUCTION
AQUA OZONE搭載の
ノーリツ商品紹介

Design Concept
除菌性能を備えたオゾン⽔を動的な雫のシルエットと、オゾン(O3)を象徴する3つの円で表現。⼒強いブルーの⾊合いは、オゾン⽔の優れた除菌⼒を⽰しています。
「AQUA OZONE」、「AQUA OZONE」マークは(株)ノーリツの登録商標です。






